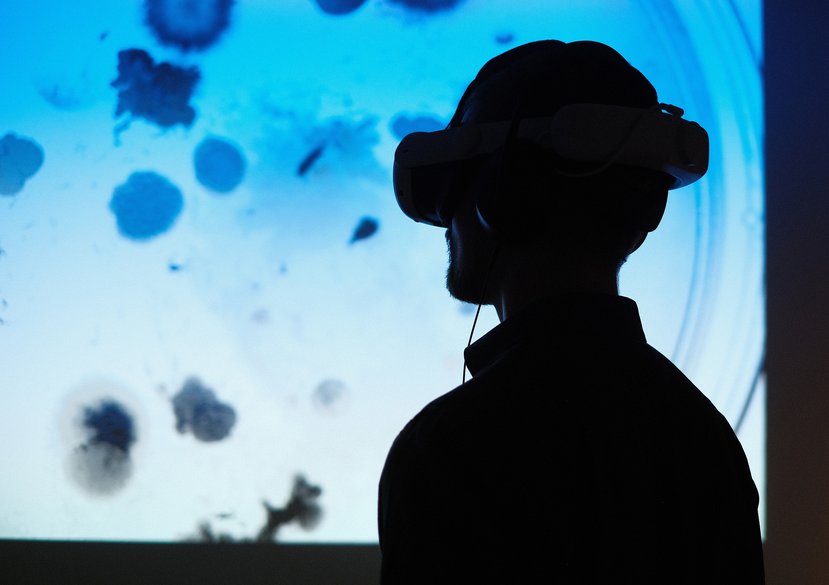
3
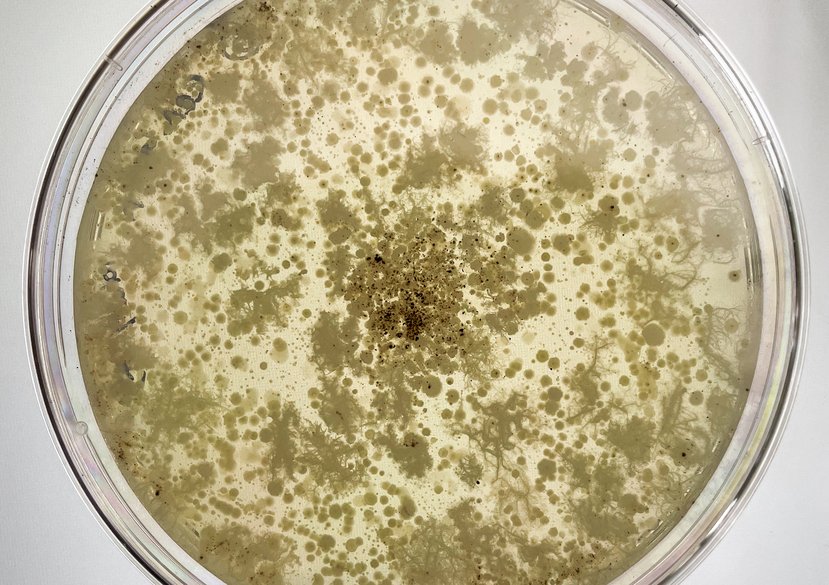
4

Carolina is an architect, designer, and researcher whose practice lies at the intersection of architecture, living systems, and critical technologies.
Carolina Ramirez-Figueroa develops creative methodologies that integrate living systems into design practices, fostering new understandings of relationality, materiality, and temporality. Through her research, Carolina seeks to create transformative experiences that provoke critical discussions on the role of design in shaping sustainable and inclusive futures.
She is a Senior Research Tutor in Information Experience Design (IED) at The Royal College of Art. She leads the Interspecies Entanglements studio, which explores how design can serve as a transformative agent by acknowledging and addressing all forms of material and environmental injustice, particularly the structural racism and extraction that have driven us into a permacrisis. Her work calls for a re-evaluation of economies, politics, and ethics through more-than-human relations, promoting respectful engagement with non-humans to reshape how we coexist.
Carolina's work explores possibilities for both desirable and cautionary futures, advocating for more-than-human ethics that foster mutual care and collaboration across species. She has led numerous research projects, partnerships, and exhibitions within the RCA, advancing interdisciplinary dialogues in design and ecology.
Key details
School, Centre or Area
Gallery
More information
Research interests
Carolina's research investigates the culture, practices, tools, and economies involved in working with and designing for living systems across various scales, from experiences and products to architecture and urban ecologies. Her work aims to imagine and deliver potential futures that challenge and provoke discussions around technological, social, cultural, political, economic, and environmental issues.
Currently, she is exploring dust as a material device to investigate temporality and understand the past and future from a microbial perspective, contributing to the concept of a non-human archive. The first iteration of her project, The Materialised Temporality of Dust, was recently exhibited at Ars Electronica.
Carolina completed her PhD by creative practice at the School of Architecture, Newcastle University, focusing on the use of living and semi-living matter in design contexts. Her thesis, Bio-material Probes: Design Engagements with Living Systems, features a series of interventions and projects that examine how design practices evolve when microorganisms are considered as design materials.
Practice
Carolina’s practice focuses on integrating living systems into design across different contexts. Her work spans material explorations, art installations, and performance-based projects, all driven by a commitment to addressing social and environmental challenges. By incorporating biological and ecological perspectives, she pushes the boundaries of traditional design, fostering innovative approaches that reflect the complexities of human existence within broader ecological and societal frameworks.
Carolina’s interdisciplinary practice draws from art, design, technology, anthropology, and the humanities, encouraging critical discourse on the role of design, technology, and living systems in shaping sustainable futures. Her work challenges conventional design paradigms by engaging with living systems—such as microorganisms and plants—to create experiences that explore the ethical and environmental implications of design.
By blurring the boundaries between human and non-human actors, Carolina’s projects encourage reflection on how humans coexist with other life forms and how design can address pressing global issues. Through this lens, she aims to provoke thought and foster dialogue on the potential of design to shape a more inclusive, sustainable, and collaborative future, where living systems and design coexist in meaningful ways.
Research funding
2024 – Reverse Alchemy. £20,000 in hardware procurement from international tech company.
2019 – 2024 - Internal RCA Funding. £4,250
2021- Luminous: Interactive and Immersive Experience Design. Funder: LG Display. £89,062
2020- Festival of the Mind, University of Sheffield, £5,000
2019- Drifter, Whisper, Trickster, UCL £3,000
2018- Research Associate, project Niches of Organic Territories in Bio-Augmented Design, which has an approximate, AHRC. £200,000
2018 – Martin Fellowship, Naturalis Biodiversity Center. €2,600, and received £1,000 for the Biomaker
2017 – Biomaker Challenge and a Bench-top Controlled Environment Growth Chamber. £5,000
2016 – Making Life, Finish Society of Bioart. £1,200
2012 – PhD studentship, AHRC and Newcastle University. £45,000
2011 - Latin America Scholarship from Newcastle University. £3,500
2004 - Excellency Award, Instituto Tecnológico y de Estudios Superiores de Monterrey (ITESM). £6,000
Awards
AHRC and Newcastle University, PhD studentship, 2012
Latin America Scholarship. Newcastle University, 2011
Excellency Award. Instituto Tecnologico y de Estudios Superiores de Monterrey, Ciudad de Mexico (ITESM). 2004
Current and recent projects
The Materialised Temporality of Dust
2023-present
The Materialised Temporality of Dust is a multidisciplinary research project that leverages dust as a material device to explore concepts of temporality and investigate the past and future from a microbial perspective. By treating dust as an active archive that encompasses both human and non-human histories, the project raises fundamental questions: How can we experience the history of a site through a microbial lens? What does a non-human archive entail?
This initiative invites audiences to engage with the concept of the pluriverse—a world of many worlds. The project's first phase immerses participants in a virtual reality and spatial sound experience, allowing them to navigate the Royal College of Art's Library not merely as humans, but as integral components of the microbial world. Through this innovative approach, participants re-experience the library, gaining insights into the intricate interactions of microbial life and the histories embedded within dust, fostering a deeper understanding of our interconnected existence. The project was recently exhibited at the Beyond the Veil: Unravelling Unseen & Unheard at Ars Electronica 2024.
The Materialised Temporality of Dust
Reverse Alchemy
2023-Present
Reverse Alchemy is a research project that brings scholars from the RCA and Korean National University of Arts to explore the future synergy between Artificial Intelligence (AI) and Extended Reality (XR) beyond conventional R&D frameworks that often dictate the trajectory of new technologies. The phrase ‘reverse alchemy’ provides a neat metaphor for intervening in technical processes to engineer their outcomes toward more organic ends.
The project proposes a series of design workshops across two institutions and geographies that invite designers and researchers to work in a blue-sky model, modelling possibilities at the intersection between XR and IA. To develop coherent proposals that enable a responsible AI and XR ecosystem that takes into consideration sustainability, human well-being and collective good, and has the potential to transform economy and society. The project secured £15,000 in hardware procurement from international tech company.
Reverse Alchemy, London, Korea
Post-Anthropocentric Design (PAD) Lab
2021-present
PADLab is a research laboratory and creative workshop, developed at the RCA and partnered with Shenkar College of Art in Tel Aviv, created as a research and practice testbed for changing human-centred perspectives through practical, accessible design-led interventions. PADLab acts as a platform for communication and collaboration between designers, researchers and policymakers and is designed to continuously strive for balance between creative and speculative work and fact-driven research and hypotheses. A forthcoming publication examines the value of multispecies collaboration and inter-species perspective-taking, specifically as a mode of destabilising existing paradigms to enable more adaptive and resilient decision-making.
NOTBAD (Niches for Organic Territories in Bio-Augmented Design)
2017-2018
NOTBAD is a multi-disciplinary research project exploring the notion of ‘Probiotic Architecture’ in which materials are ‘seeded’ with beneficial microbes to modify the microbiome of its users. The project looks at fabrication techniques to control the chemical makeup of materials and their porosity landscapes, optimising them to host specific bacterial species. The microbial communities in each material are fostered to outcompete microbes that cause diseases and prevent the development of ‘super-bugs’ that are resistant to antibiotics. NOTBAD takes a humanistic and design-led approach in looking at the integration of seeded materials into wider cultural narratives and imaginaries of health, disease, and filth. The project was exhibited at the Biological Buildings exhibition at the Barbican Centre in 2019.
Biomaterial Probes, Design Engagements with Living systems
2012-2017
Biomaterial Probes is a research project that explores the possibility and consequences of integrating living systems into the processes of design and fabrication in architecture. It raises the question: what methods and ways of exploration are needed to engage directly with living systems to uncover design possibilities? To explore this research question, it proposes a creative methodology of biomaterial probes: design situations that provide the context to explore the design potential of biological systems, but that suspend the requirement for a practical design outcome at the outset. As part of the exploration, four biomaterial probes are mobilised to define different approaches to designing form with living systems, starting with parametrics and evolving towards an approach that considers non-human agency and assemblages.
Publications, exhibitions, other outcomes
Selected Publications
2024
Carolina Ramirez-Figueroa, Antony Nevin and Campbell Orme. The materialised temporality of dust (2024) In Research Directions: Biotechnology Design. Cambridge University Press [In Press]
Barrios-O’Neill, D., Ramirez-Figueroa, C., Jarvis, C., Dudek, L., Ben-Meir, N.B., Falomo, E., Pauzner, M. and Kutok, O. (2023). “Systems Play: Using Experimental Art and Design Methods to Empower Systems Change.” [submitted, under review]
Carolina Ramirez-Figueroa, Gian Luca Amadei, Nirit Binyamini Ben-Meir , Cecilia Martin and Adam Kaasa, (2024)Experience as a transformational practice Vol. 6 No. 2 (2024): GLAD-HE 2023 Post-Symposium Publication: Gathering Ourselves
Carolina Ramirez-Figueroa and Michal Pauzner (2024), Entanglements of Care. In 100 Years of Care (ed. Rodgers P, Bremmer C). AHRC
Hadas Zohar, Nirit Binyamini Ben-Meir, Carolina Ramirez-Figueroa, Danielle Barrios-O’Neill, Michal Pauzner, Oded Kutok, Laura Dudek, and Erin Robinson (2024). Design Methods for Accessing the Pluriverse. In Companion Publication of the 2024 ACM Designing Interactive Systems Conference (DIS '24 Companion). Association for Computing Machinery, New York, NY, USA, 417–420.
2023
Luis Hernan and Carolina Ramirez-Figueroa (2023) A Home with a Future. Digital Domesticity and the Vague Fictions of Silicon Valley, Architecture and Culture.
Gizem Oktay, Yuta Ikeya, Minha Lee, Bahareh Barati, Youngsil Lee, Yuning Chen, Larissa Pschetz, and Carolina Ramirez-Figueroa. (2023) Designing with the more-than-human: Temporalities of thinking with care. In Companion Publication of the 2023 ACM Designing Interactive Systems Conference (DIS ‘23 Companion). Association for Computing Machinery, New York, NY, USA, 104–106.
2022
Barrios-O’Neill, Danielle, Dudek, Laura, Ben Meir, Nirit Binyamini, Falomo, Elena, Jarvis, Charlotte and Ramirez-Figueroa, Carolina (2022) Navigating Wicked Futures Through More-Than-Human Perspectives: Experiments in design education. In: Proceedings of Relating Systems Thinking and Design, RSD11, 3-16 Oct 2022, Brighton, United Kingdom
Hernan, Luis and Carolina Ramirez-Figueroa, “A Luminous Abstraction: 5G Narratives and Futuring Otherwise,” Mediapolis: A Journal of Cities and Culture 7, no. 3 (2022), https://www.mediapolisjournal.com/a-luminous-abstraction-5G-narratives
Pschetz, L., Ramirez-Figueroa, C., and Revans, J. (2022) Learning from creative biology: Promoting transdisciplinarity through vocabularies of practice, in Lockton, D., Lenzi, S., Hekkert, P., Oak, A., Sádaba, J., Lloyd, P. (eds.), DRS2022: Bilbao, 25 June - 3 July, Bilbao, Spain
Välk, S. et al. (2022). Narratives in Biodesign – Bridging Methods, Processes and Tools. In: Bruyns, G., Wei, H. (eds) [ ] With Design: Reinventing Design Modes. IASDR 2021. Springer, Singapore.
2021
Luis Hernan & Carolina Ramirez-Figueroa (2021) Time is out of Joint: Digital Domesticity and Magical Realism, Journal of Architectural Education, 75:2, 184-191
Phillip Gough, Jack Forman, Pat Pataranutaporn, Leigh-Anne Hepburn, Carolina Ramirez-Figueroa, Clare Cooper, Angela Vujic, David Sun Kong, Raphael Kim, Pattie Maes, Hiroshi Ishii, Misha Sra, and Naseem Ahmadpour. 2021. Speculating on Biodesign in the Future Home. In Extended Abstracts of the 2021 CHI Conference on Human Factors in Computing Systems (CHI EA ‘21). Association for Computing Machinery, New York, NY, USA, Article 77, 1–5.
Phillip Gough, Larissa Pschetz, Naseem Ahmadpour, Leigh-Anne Hepburn, Clare Cooper, Carolina Ramirez-Figueroa, and Oron Catts. 2020. The Nature of Biodesigned Systems: Directions for HCI. In Companion Publication of the 2020 ACM Designing Interactive Systems Conference (DIS’ 20 Companion). Association for Computing Machinery, New York, NY, USA, 389–392.
Välk, S. et al. (2022). Narratives in Biodesign – Bridging Methods, Processes and Tools. In: Bruyns, G., Wei, H. (eds) [ ] With Design: Reinventing Design Modes. IASDR 2021. Springer, Singapore.
Hernan, L. and Ramirez-Figueroa, C. (2021) Domesticity and digital eugenics : design cultures of Silicon Valley. In:Design Culture(s). Cumulus Conference Proceedings Roma 2021, Volume #2. , pp. 4542-4550.
Ramirez-Figueroa, C. and Hernan, L. (2021) Bio-revolutions : radical change, design cultures and non-humans. In: Design Culture(s). Cumulus Conference Proceedings Roma 2021, Volume #2, pp. 1208-1221.
2020
Ramirez-Figueroa C, Beckett R (2020), Living with buildings, living with microbes. Probiosis and architecture, Architectural Research Quarterly, Cambridge University Press
Ramirez-Figueroa C, Hernan L, Lin, P (2020). Living Ashes: Associated Milieus and Distributed Agencies. Special Number on Microperformativity, Performance Research, Routledge
Ramirez-Figueroa C, Watt T. (2020), Despite the optimistic predictions for the Design of Care, what does the doing of care really do? in Does Design Care...?! (ed. Rodgers P, Bremmer C, Innella G). Lancaster University ISBN: 978-1-86220-372-3.
2019
Ramirez-Figueroa C. (2019), P is for Puzzlement in An Illustrated* A to Z for the Design of Care (ed. Rodgers P, Bremmer C, Innella G). Lancaster University.
Beckett, R., Nair, S., Ramirez-Figueroa C. (2019), NOTBAD in Design Research for Change 2019 (ed. Rodgers P, Bremmer C, Innella G). Lancaster University. ISBN: 978-1-86220-363-1.
2018
Ramirez-Figueroa C., Hernan L., Pei-Ying L., The biological unseen: producing and mediating imaginaries of protocells In: The Latent Image 2018, 5th international conference on trandisciplinary imaging at the intersection of art, science and culture, April 2018 Edinburgh
Hernan L, Ramirez-Figueroa C., The technological invisible: image making as an exercise of power In: The Latent Image 2018, 5th international conference on trandisciplinary imaging at the intersection of art, science and culture, April 2018, Edinburgh
2017
Dade-Robertson M., Ramirez-Figueroa C. and Hernan L. (2017) Bio-materialism: Experiments in biological material computation In: New Disciplines of Making – Shared Knowledge in Doing: Research through Design Conference. March 2017, Edinburgh
2016
Ramirez-Figueroa C., Hernan L., Guyet A. and Dade-Robertson M. (2016) Bacterial Hygromorphs: material proxies as design pedagogy to engage with living technologies. In: ACADIA 16: Posthuman Frontiers [Proceedings of the 36th Annual Conference of the Association for Computer Aided Design in Architecture (ACADIA).
Dade-Robertson M., Mitrani H., Wipat A., Zhang M., Corral J., Ramirez-Figueroa C. and Hernan L. (2016) Thinking Soils: A Synthetic Biology approach to material based design computation. In: ACADIA 16: Posthuman Frontiers [Proceedings of the 36th Annual Conference of the Association for Computer Aided Design in Architecture (ACADIA).
2014
Dade-Robertson M., Ramirez-Figueroa C. and Zhang M. (2014) Material Ecologies for Synthetic Biology: Bio-mineralization and the state space of design. Computer Aided Design, Special Edition on Material Ecology Design and Computational Issues
Dade-Robertson M., Ramirez-Figueroa C. and Zhang M. (2014). Radical Vernacular: Bacterial Architecture on Mars. JBIS: Journal of the British Interplanetary Society, 67.
2013
Dade-Robertson M., Zhang M., Ramirez-Figueroa C., Hernan L., Beattie J., Lyon A., Ryden M. and Welford M. Proto-materials: Material Practices in Architecture at Molecular and Cellular Scales. In: Michael Stacey, ed. Prototyping Architecture. London: Building Centre Trust, 2013, pp.211-223.
Ramirez-Figueroa C., Dade-Robertson M. and Zhang M. Synthetic Biology as a material design practice. In: Praxis and Poetics: Research through Design Conference. September 2013, Newcastle.
Ramirez-Figueroa C. and Dade-Robertson M. (2013) Adaptive Morphologies: Towards a Morphogenesis of Material Construction. In: ACADIA 13: Adaptive Architecture [Proceedings of the 33rd Annual Conference of the Association for Computer Aided Design in Architecture (ACADIA) .
2012
Ramirez-Figueroa C. and Dade-Robertson M. Recombinatorial personal spaces of knowledge. In Digital Research. 2012, Oxford, UK.
Selected Exhibitions and performances
(2024) Beyond the Veil: Unravelling Unseen & Unheard Narratives, Ars Electronica, Linz, Austria
(2024) Colour made manifesto, Pumphouse, Batterse Park, London UK
(2019) Drifter, Whisper, Trickster in Festival of the Mind, Sheffield, UK Whisper Drifter Whisper
(2019) Biological Buildings, The Barbican Centre, London, UK
(2018) Living with adaptive architecture, Lakeside Arts Centre, Nottingham, UK
(2017) Bio-material probes, design engagements with living systems. Newcastle University, UK
(2016) Living ashes II performance
CLICK Festival, Contemporary art, science & technology, Helsingør, DK
(2016) Bio Apartment 3—Succession. National Taiwan Museum, Nanmen Park, Taiwan
(2015) Making Life, Living ashes. Lasipalatsi Gallery, Helsinki
(2014) Ordinary Takeover. Architectural Association, School of Architecture, London, UK
(2013) Praxis and poetics. Baltic Centre for Contemporary Art, Newcastle, UK
(2005) Designs from the Future. MUNAL Museo Nacional de Arte, Mexico City, Mx
External collaborations
Member of the RCA Honours Committee (2024 to date)
Member of the RCA Senate (2022 -to date)
RCA representative, London Doctoral Design Centre (2019-2022)
Finish Bioart Society (2014-2015)
Syn.de.bio network. (2014-2016)